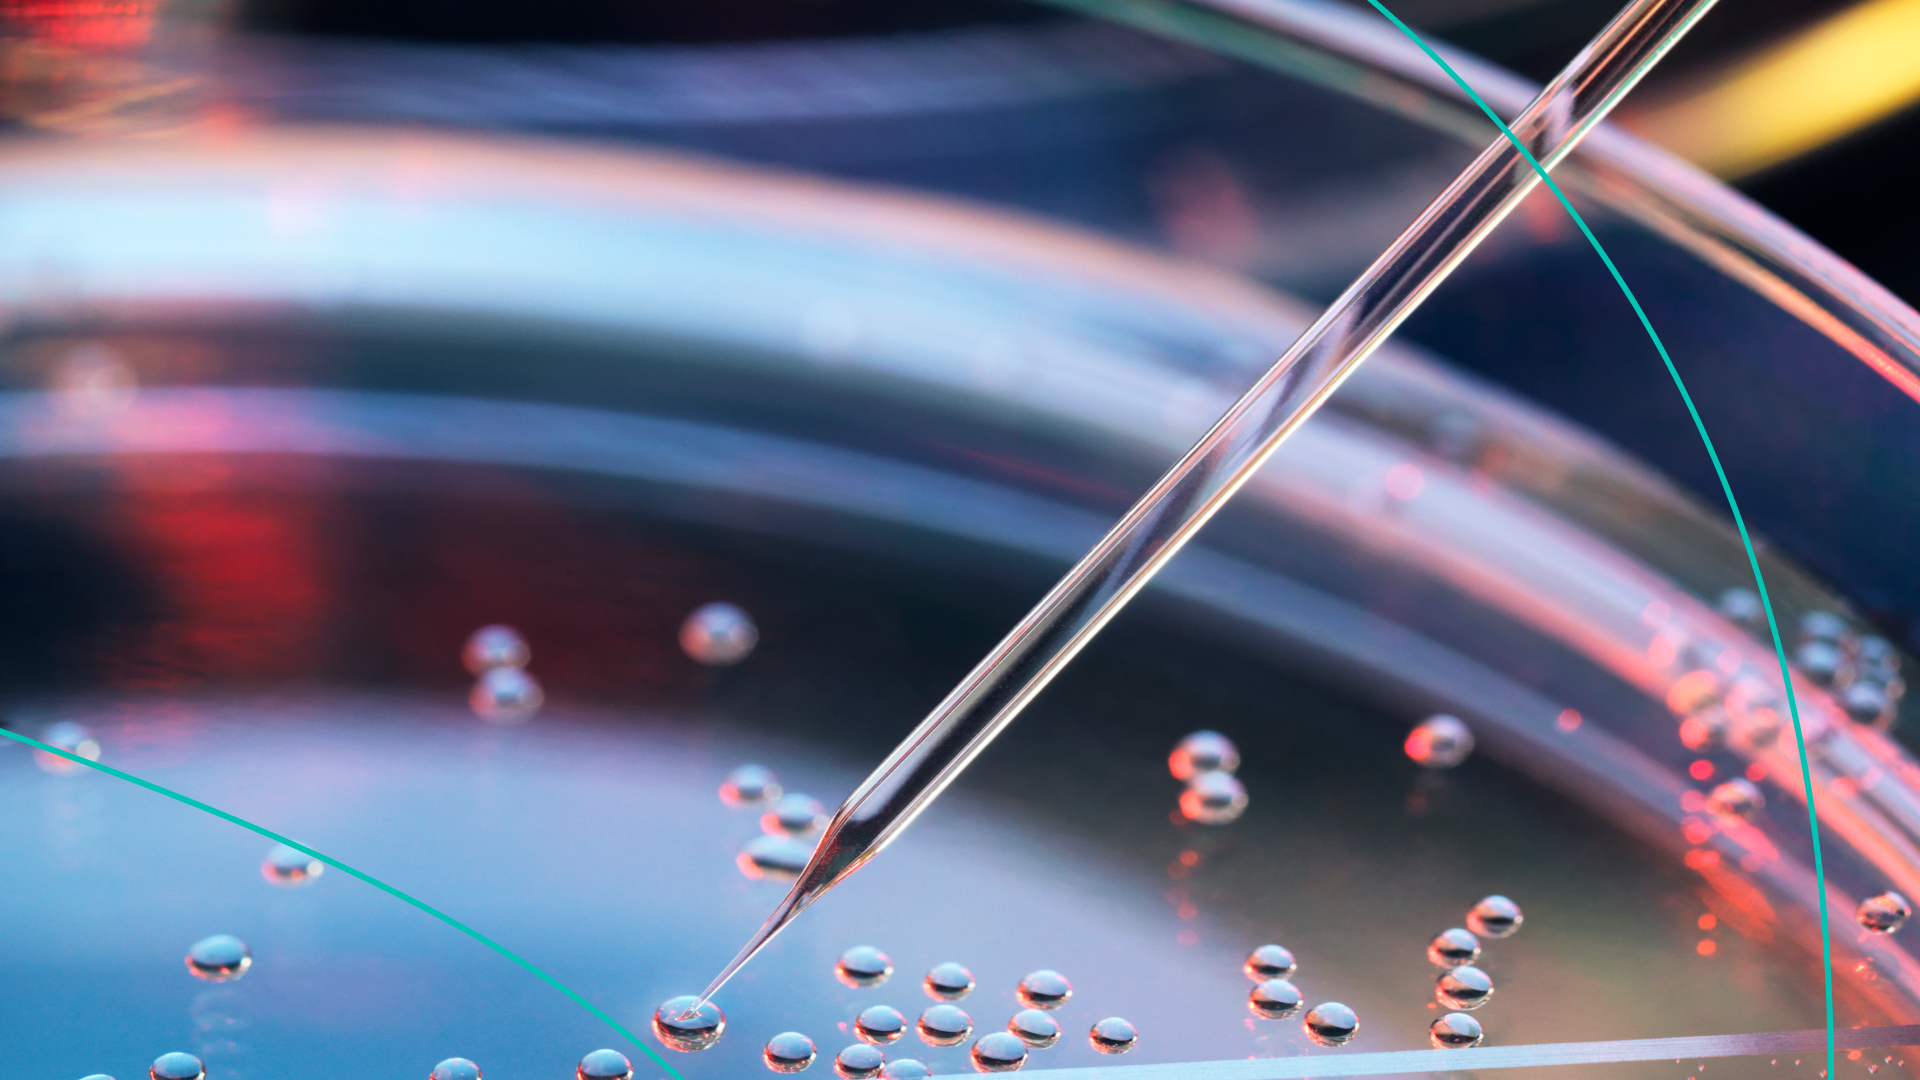

| ||||||||||||||||||||||||||||||||||||||||||||||||||||||||||||||||||||||||||
Cinema Latest
- 20 Unmarried Serial Actress
- Actress Disha Patani
- Actress Janhvi Kapoor
- Actress Oviya
- Actress Shreya Saran
- AK Sexy Fashion
- Alia Bhatt
- Amala Paul Hot Compilation
- Amy Jackson Old Pics
- Aranmanai 3 Movie
- Bd actress purnima hot dance
- Bigg Boss Tamil Season 5
- Bollywood Actress Hot
- Bollywood Actress Most Beautiful Dress
- Breathe | Pinky
- Doctor Movie Review
- Full Romantic Hindi Movie
- Heroine Tabu Super Hit Movie House Cleaning Scene
- Indian new hot and romentic model
- Janhvi Kapoor
- Madhu Serial Actress
- Metti Oli Uma Maheswari
- New Picture of Keerthi Suresh (Tamil Cinema Gallery 2017)
- Nivetha Pethuraj hot photoshoot video
- Pelli Sandadi Movie Heroine Sreeleela Gorgeous Look
- Pooja Hedge
- Raashi Khanna Pics
- Sakshi Chaudhary hot vertical
- Sassy Poonam
- Sassy Poonam Suhana khan
- Shalu Kurian
- Shilpa Shetty So Sweet
- Sofia Ansari
- sufia Ansari Sassy Poonam
- Suhana Khan hot photoshoot video | Desi tiktok queen with milky assets
- Tamanna Dance
- Tamil Girls Video
- Telugu Latest Intresting Movie Scene
- Terrifying Spotlight of an HBO
- Tik Tok Hot Video
- Trending Instagram Videos
- Vijay Sing New Song Aniruth Music
Tamil Song Lyrics
Synthetic Embryos, Jordan Neely, and Beyoncé
Blog Archive
-
▼
2023
(1185)
-
▼
June
(117)
- The FTC and Microsoft have had A Week™
- The best Fourth of July sales to shop right now
- Movies Update: ‘Indiana Jones’ and More
- Independence Day Savings Are Here! 🇺🇸
- In 'Dial of Destiny,' a franchise strains to keep up
- In Stock Alert
- It's not all about the dresses and crowns
- Is it time to boycott streaming services?
- You've got a feeling
- New Color Alert
- Join Our Perfect Community
- Taylor Mac doc covers a queer 24 decades of music
- They go uhoh
- I need to ask you this...
- Red Hot Chili Peppers' Flea on God, music and more
- I’m the flavor of the decade
- Our Bestselling Sets are Back in Stock
- Your favorite stars are on The Envelope Roundtable
- New laws help Hollywood with taxes and set safety
- Strawberries on a summer evening
- our 🍫 is available nationwide
- 'Cause I'm going to Strawberry Fields
- Jason Segel's middle-aged problems
- Summer's Here! ☀️
- Weekend: You’re looking so well, darling
- Bookforum is back!
- Re: Your Weekend Plans
- Movies Update: ‘No Hard Feelings’ and More
- The console wars are back, if they ever left, and ...
- Live sports could be a game changer for Netflix
- I read your horoscope
- A defiant act became a musical celebrating Latinos
- In June after dark
- A Hint of Mint
- Skims, Rhode, Hoka, and more buzzy brands
- theSkimm wants to hear from you
- Aisha Harris' 'Wannabe' book muses on pop culture
- Lay back, it's all been done before
- Today Only: Save 15% Sitewide!
- Apple and Disney could shape the future with VR
- Daily Skimm: My friends say I should act my age
- One Hit Wonders
- Check out The Envelope Drama Roundtable
- Mark Taper Forum pause reflects a regional crisis
- Juneteenth, Reparations, and Reading Recs
- Calling all cool dads ⏰
- GUESS WHAT'S INSIDE
- Happy Father's Day!
- Social Media News, Instant Pot, and Outer Space
- Streaming's hits, misses and what's next
- Oui, oui, Paris!
- We let Chat GPT write this e-mail
- The best of the best in beauty
- For every kind of father figure
- Special Olympics World Games, Dadfluencers, and As...
- The time Tony Soprano gave Jessica Chastain advice
- Back in Stock in New Colors
- Summer Game Fest might be over, but there's plenty...
- Movies Update: ‘The Flash,’ ‘Elemental’ and More
- Lewis Black is angry, but he's happy to see you
- Junk Fees, SCOTUS, and Doja Cat
- Up next: Southampton
- How fans ‘game the system’ to save favorite shows
- Synthetic Embryos, Jordan Neely, and Beyoncé
- On Our Watchlist: Steamy romances, epic battles, a...
- Watch now: The Envelope Comedy Roundtable
- Streaming's boom-and-bust cycle hit animators hard
- Inflation, Former President Trump, and “Up”
- Malibu bound
- John Mellencamp shows no signs of cheering up
- Book Bans, JPMorgan Chase, and Pedro Pascal
- Discover The Envelope this awards season 🎬 🏆
- Moms Who Get It: Recs for surviving summer
- How 'The Flash' hopes to dodge Ezra Miller drama
- Trump's Indictment, Colombia, and the Tony Awards
- Time for takeoff
- PGA Tour and LIV Golf, Hollywood Strikes, and Game...
- Vidiots welcomes back L.A. moviegoers after six years
- UNLOCK A SECRET MRBEAST VIDEO
- What kind of pants do goats wear? Billie Jeans 😏
- Why this heartthrob went indie for his film debut
- Day to night dressing
- Gendered Prizes, Beige Flags, and Adult Summer Camps
- click this email to win 50% off
- Movies Update: ‘Transformers’ and More
- All the Summer Game Fest game reveals
- Rhiannon Giddens programs a risky Ojai Festival
- Trump, Louisiana, and Tom Holland
- How do comedians in L.A. make a living?
- Smoky skies, Parkland, and Fireball
- Mix and Match Linen
- Skimm Faves: Laundry care, the best sunscreens, an...
- we gave away a $10,000 taylor swift ticket
- Nothing was off limits in the 'Arnold' documentary
- Prince Harry, Florida, and Pete Davidson
- Latest 'Transformers' film marks a fallen franchise
- Binance, Hormone Patches, and Apple
- The reviews are in
- Father’s Day gifts to split with your siblings
- 'Spider-Man: Across the Spider-Verse' opens huge
- Every word you say is like a warm cuddle
- For all the father figures in your life
- It's Real Men of Jeanius Contest Time
- Weekend: Gardenias floating through daydreams
- It's Emmys season. Here's your viewing guide
- Back in Stock
- Welcome to Firstpost's Weekly Foreign Policy Fix
- Weekend: Come ride with me to the distant shore
- Remembering songwriter Cynthia Weil
- A Breath of Fresh Air
- Diablo 4, Street Fighter 6, and Spider-Man
- Movies Update: ‘Spider-Man: Across the Spider-Vers...
- Comedians take L.A.'s Roast Battle League global
- So are you like a cow or a dalmatian?
- Image is back with ‘Clearance’
- 'Transparent' musical builds on the show's legacy
- A lucky, lucky girl
-
▼
June
(117)